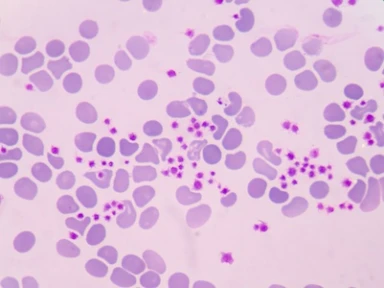
The pathophysiology of ITP stems from complex immune dysregulation drives thrombocytopenia and inflammation

Welcome to Campus Sanofi Qatar
Access all the content and events you need to continue growing as a health professional.
More about science
Acquired Thrombotic Thrombocytopenic Purpura (ATTP)
Asthma
Atopic Dermatitis
Cardiovascular
Chronic Obstructive Pulmonary Disease
Diabetes
Eosinophilic Esophagitis
Multiple Sclerosis
Nasal Polyps
Multiple Myeloma
Prurigo Nodularis
Rare Diseases
Vaccines
Latest trends
Explore the most popular scientific articles and videos among Campus Sanofi users
Events
Stay up to date and register for the latest events and view webinar recordings
Support for your patients
Discover the selection of support materials for patients from different therapeutic areas
Sanofi in News
Discover headline news on how Sanofi is engaged with the medical community

.webp/jcr:content/salah%20(1).webp)
















